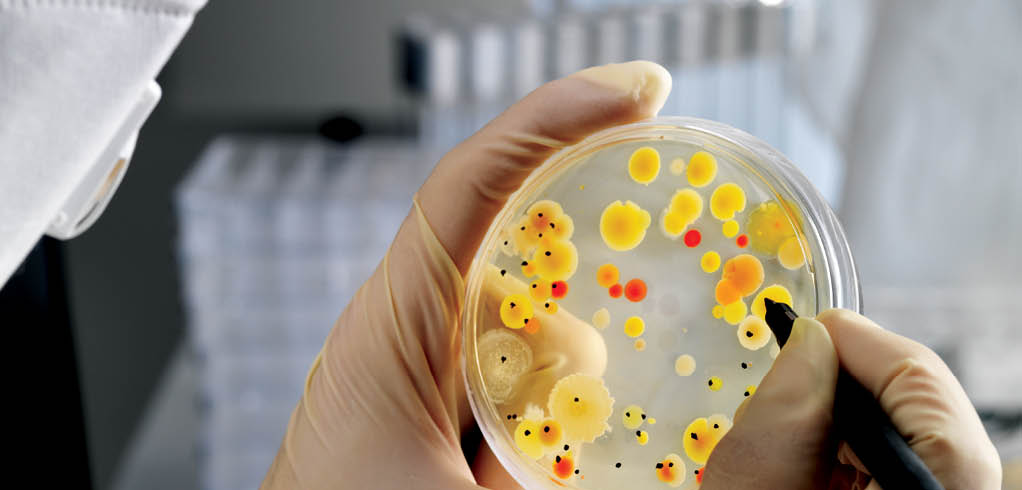

Maintaining Quality and Compliance Through Environmental and Lab Monitoring
For biologics, maintaining stringent environmental control is paramount to ensure the safety and integrity of products, especially given the sensitive nature of biological materials. Our environmental monitoring solutions allow manufacturers to track and manage airborne contaminants and other critical parameters in real-time, helping to prevent potential product contamination. Coupled with our lab monitoring and control systems, which facilitate stringent safety protocols and energy efficiency, our equipment empowers clients to maintain regulatory compliance and uphold the highest standards of product quality. This comprehensive approach to monitoring allows biologics manufacturers to confidently manage their production environments and protect the purity of their products.
Supporting Drug Delivery Precision and Efficacy
Our advanced equipment for Aerodynamic Particle Size Distribution (APSD) and Delivered Dose Uniformity (DDU) testing is designed to ensure that biologics manufacturers can achieve optimal drug delivery. APSD testing plays a critical role in verifying that inhaled drugs can effectively reach the lungs’ target areas, an essential factor for respiratory treatments. With DDU, we support manufacturers in delivering medication with precision and consistency, ensuring each dose remains within the desired specifications. This precision not only improves patient outcomes but also helps our clients meet regulatory standards, paving the way for safer and more reliable inhaler and nasal drug products.
Enhancing Drug Development and Research Efficiency
The path from research to market for biologics can be complex, requiring precise data and effective models that predict real-world behavior. Our gas flow measurement solutions optimize the development of medical devices, enabling research teams to gather accurate data on device performance and improve design efficiency. Additionally, our In Vitro In Vivo Correlation (IVIVC) testing tools bridge the gap between lab results and clinical outcomes, helping to predict a drug’s performance once it reaches the market. By providing these advanced tools, we support our clients in accelerating the drug development process, reducing time-to-market, and ensuring that new therapies are safe and effective.

_preview-image_256x1952e179.jpg?width=256&height=195&ext=.jpg)


-application_preview-image_256x195e179.jpg?width=256&height=195&ext=.jpg)
